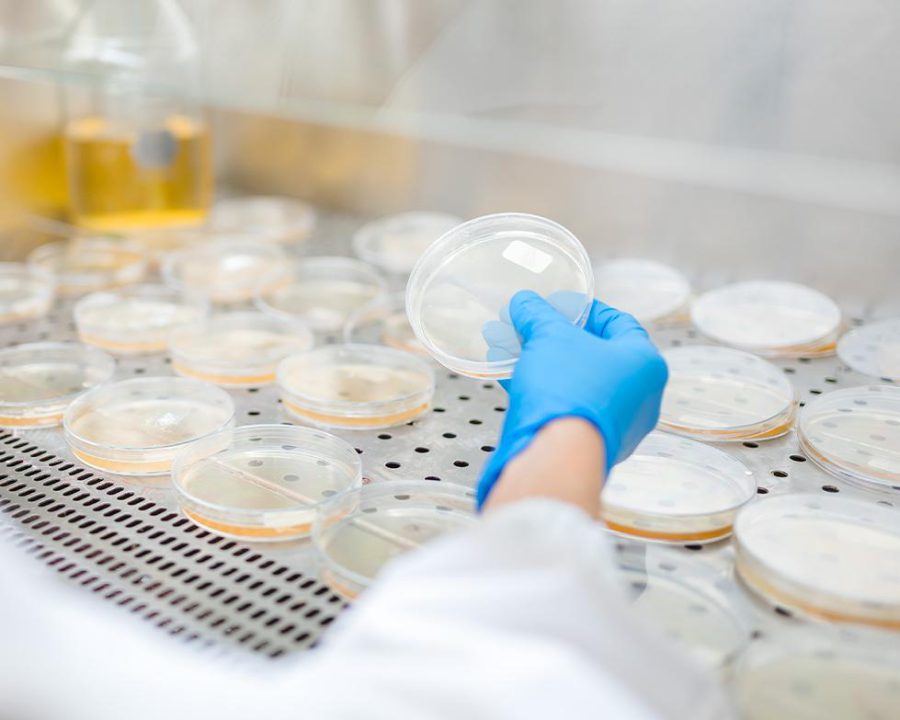
azienda Prochemia laboratorio di analisi microbiologiche

Assistenza completa conun team professionaleal tuo fianco
Prochemia è un laboratorio di analisi chimiche e microbiologiche dall’esperienza pluriennale. Siamo in grado di soddisfare, con accuratezza, puntualità e rapidità, qualunque richiesta analitica nei settori agroalimentare, cosmetico/nutraceutico, ambientale e dei beni di consumo.
Accreditato (ISO 17025:2018) per l‘esecuzione di diverse analisi in campo cosmetico, agroalimentare e ambientale, inserito nell’elenco dei laboratori autorizzati dalla Regione Lombardia.
Prochemia ha da sempre improntato la propria attività su due punti fermi: assistenza al cliente e rapidità di analisi, ponendosi, con il proprio team specializzato “vicino al cliente “, assistendolo nelle sue necessità quotidiane e nelle decisioni più strategiche in materia di sicurezza.

Prochemia garantisce un servizio rapido e accurato unendo un approccio volto alla relazione a lungo termine con il cliente, instaurando un vero rapporto tra “partners”.
Un “tutor” esperto e qualificato affianca il cliente fin dalle prime fasi rispondendo alle sue richieste in modo puntuale, mirato e competente.
Il laboratorio, garantisce l’applicazione di procedure armonizzate e riconosciute a livello internazionale. Prochemia controlla ogni fase del processo analitico, dall’accettazione del campione fino all’emissione del rapporto di analisi.
Il nostro Team, in costante aggiornamento, è in grado di supportarvi offrendo: assistenza, riservatezza, trasparenza e affidabilità su problematiche relative all’analisi, alla ricerca e sviluppo, al controllo qualità e aspetti regolatori.
L’azienda si avvale delle più moderne attrezzature analitiche. Esse sono in grado sia di sostenere intensi carichi di analisi giornaliere (di routine) che di risolvere qualunque problematica che può compromettere la sicurezza del prodotto cosmetico.
Eseguiamo analisi nei seguenti campi:
Valuta quale dei nostri servizi di analisi e test corrisponde alle tue necessità
Cosmetica
Biocidi
Ambientale
